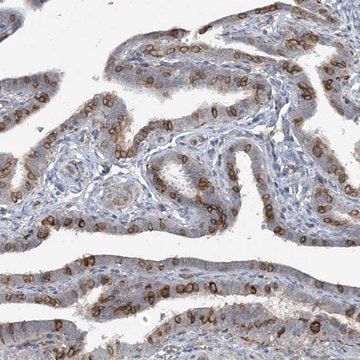
Img

HPA036178
Anti-UMPS antibody produced in rabbit
Prestige Antibodies® Powered by Atlas Antibodies, affinity isolated antibody, buffered aqueous glycerol solution
Manufacturer: Sigma Aldrich
Synonym(S): Anti-Uridine monophosphate synthηse
Select a Size
| Pack Size | SKU | Availability | Price |
|---|---|---|---|
| 100 μL | HPA036178-100-μL | In Stock | ₹ 48,995.40 |
HPA036178 - 100 μL
In Stock
Quantity
1
Base Price: ₹ 48,995.40
GST (18%): ₹ 8,819.172
Total Price: ₹ 57,814.572
biological source
rabbit
Quality Level
100
conjugate
unconjugated
antibody form
affinity isolated antibody
antibody product type
primary antibodies
clone
polyclonal
product line
Prestige Antibodies® Powered by Atlas Antibodies
form
buffered aqueous glycerol solution
species reactivity
rat, human, mouse
enhanced validation
RNAi knockdownLearn more about Antibody Enhanced Validation
Description
- Immunogen: uridine monophosphate synthetase recombinant protein epitope signature tag (PrEST)
- Application: All Prestige Antibodies Powered by Atlas Antibodies are developed and validated by the Human Protein Atlas (HPA) project and as a result, are supported by the most extensive characterization in the industry. The Human Protein Atlas project can be subdivided into three efforts: Human Tissue Atlas, Cancer Atlas, and Human Cell Atlas. The antibodies that have been generated in support of the Tissue and Cancer Atlas projects have been tested by immunohistochemistry against hundreds of normal and disease tissues and through the recent efforts of the Human Cell Atlas project, many have been characterized by immunofluorescence to map the human proteome not only at the tissue level but now at the subcellular level. These images and the collection of this vast data set can be viewed on the Human Protein Atlas (HPA) site by clicking on the Image Gallery link. We also provide Prestige Antibodies® protocols and other useful information.
- Features and Benefits: Prestige Antibodies® are highly characterized and extensively validated antibodies with the added benefit of all available characterization data for each target being accessible via the Human Protein Atlas portal linked just below the product name at the top of this page. The uniqueness and low cross-reactivity of the Prestige Antibodies® to other proteins are due to a thorough selection of antigen regions, affinity purification, and stringent selection. Prestige antigen controls are available for every corresponding Prestige Antibody and can be found in the linkage section.Every Prestige Antibody is tested in the following ways:IHC tissue array of 44 normal human tissues and 20 of the most common cancer type tissues.Protein array of 364 human recombinant protein fragments.
- Linkage: Corresponding Antigen APREST79328
- Physical form: Solution in phosphate buffered saline, pH 7.2, containing 40% glycerol and 0.02% sodium azide.
- Legal Information: Prestige Antibodies is a registered trademark of Merck KGaA, Darmstadt, Germany
SAFETY INFORMATION
WGK
WGK 1
Flash Point(F)
Not applicable
Flash Point(C)
Not applicable
Compare Similar Items
Show Difference
biological source: rabbit
Quality Level: 100
conjugate: unconjugated
antibody form: affinity isolated antibody
antibody product type: primary antibodies
clone: polyclonal
product line: Prestige Antibodies® Powered by Atlas Antibodies
form: buffered aqueous glycerol solution
species reactivity: rat, human, mouse
enhanced validation: RNAi knockdownLearn more about Antibody Enhanced Validation
biological source:
rabbit
Quality Level:
100
conjugate:
unconjugated
antibody form:
affinity isolated antibody
antibody product type:
primary antibodies
clone:
polyclonal
product line:
Prestige Antibodies® Powered by Atlas Antibodies
form:
buffered aqueous glycerol solution
species reactivity:
rat, human, mouse
enhanced validation:
RNAi knockdownLearn more about Antibody Enhanced Validation
biological source: rabbit
Quality Level: 100
conjugate: unconjugated
antibody form: affinity isolated antibody
antibody product type: primary antibodies
clone: polyclonal
product line: Prestige Antibodies® Powered by Atlas Antibodies
form: buffered aqueous glycerol solution
species reactivity: human
enhanced validation: orthogonal RNAseqLearn more about Antibody Enhanced Validation
biological source:
rabbit
Quality Level:
100
conjugate:
unconjugated
antibody form:
affinity isolated antibody
antibody product type:
primary antibodies
clone:
polyclonal
product line:
Prestige Antibodies® Powered by Atlas Antibodies
form:
buffered aqueous glycerol solution
species reactivity:
human
enhanced validation:
orthogonal RNAseqLearn more about Antibody Enhanced Validation
biological source: rabbit
Quality Level: 100
conjugate: unconjugated
antibody form: affinity isolated antibody
antibody product type: primary antibodies
clone: polyclonal
product line: Prestige Antibodies® Powered by Atlas Antibodies
form: buffered aqueous glycerol solution
species reactivity: human
enhanced validation: recombinant expressionLearn more about Antibody Enhanced Validation
biological source:
rabbit
Quality Level:
100
conjugate:
unconjugated
antibody form:
affinity isolated antibody
antibody product type:
primary antibodies
clone:
polyclonal
product line:
Prestige Antibodies® Powered by Atlas Antibodies
form:
buffered aqueous glycerol solution
species reactivity:
human
enhanced validation:
recombinant expressionLearn more about Antibody Enhanced Validation
biological source: rabbit
Quality Level: 100
conjugate: unconjugated
antibody form: affinity isolated antibody
antibody product type: primary antibodies
clone: polyclonal
product line: Prestige Antibodies® Powered by Atlas Antibodies
form: buffered aqueous glycerol solution
species reactivity: human
enhanced validation: recombinant expressionLearn more about Antibody Enhanced Validation
biological source:
rabbit
Quality Level:
100
conjugate:
unconjugated
antibody form:
affinity isolated antibody
antibody product type:
primary antibodies
clone:
polyclonal
product line:
Prestige Antibodies® Powered by Atlas Antibodies
form:
buffered aqueous glycerol solution
species reactivity:
human
enhanced validation:
recombinant expressionLearn more about Antibody Enhanced Validation